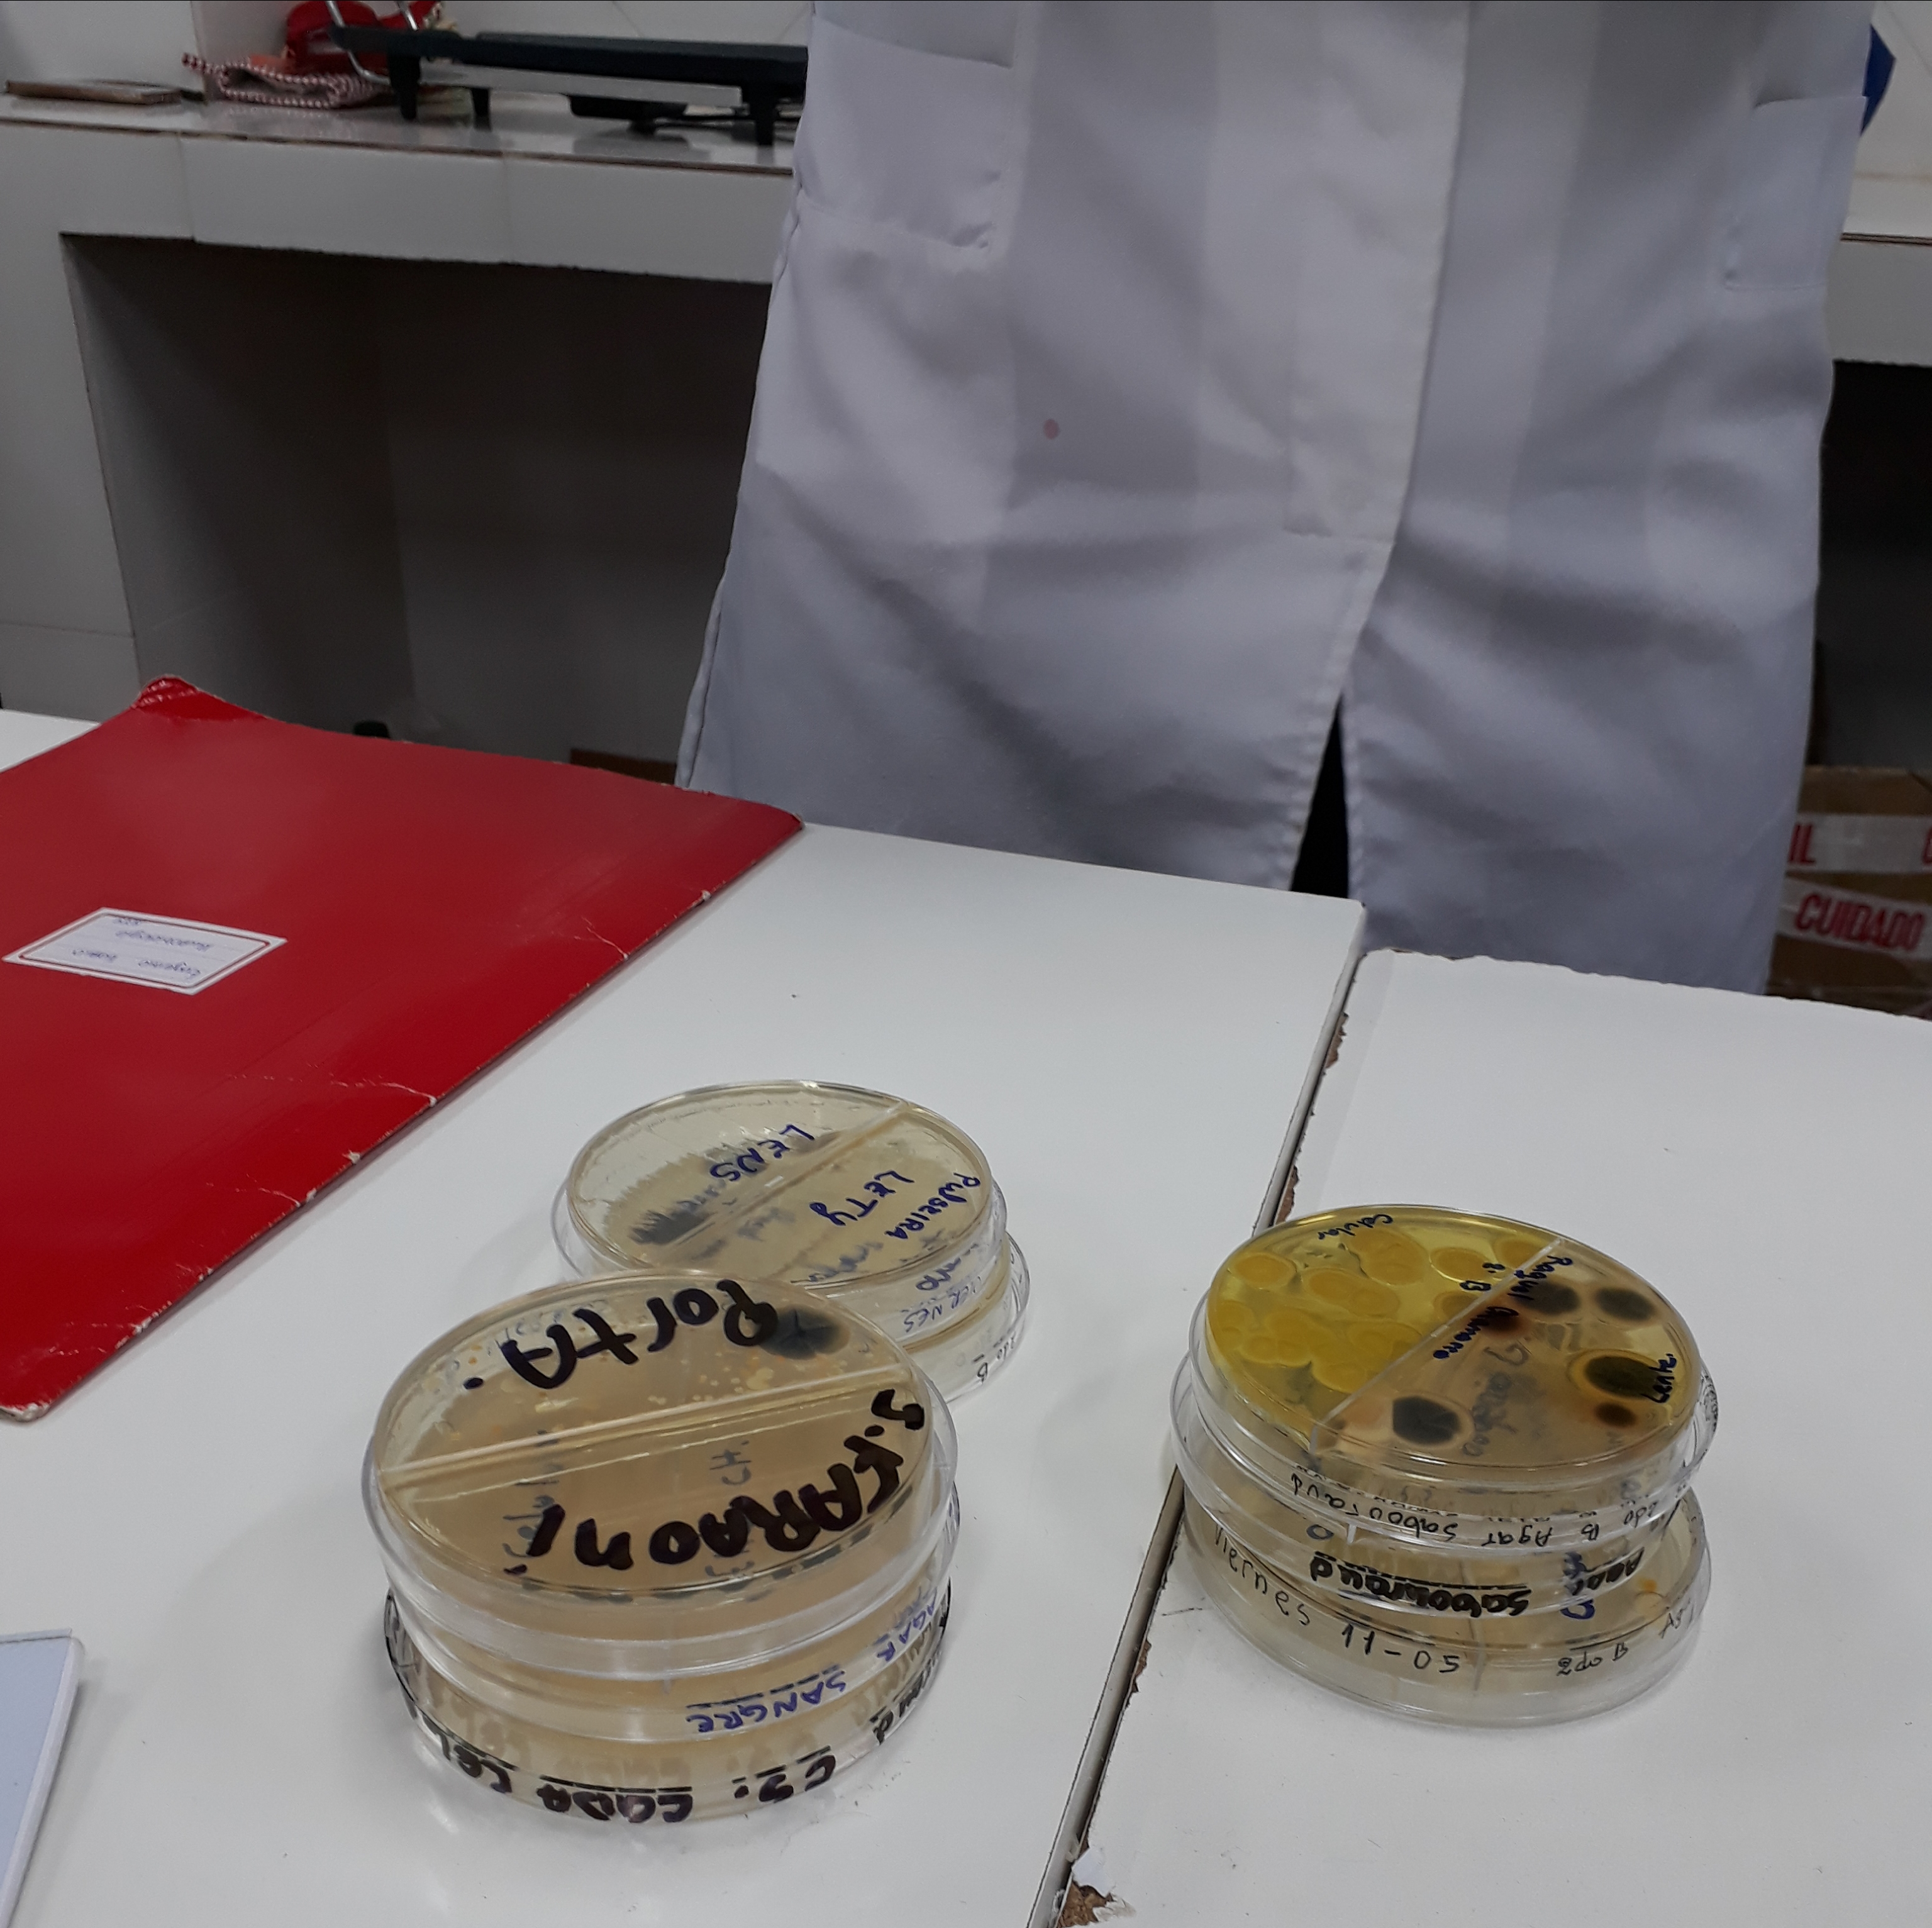
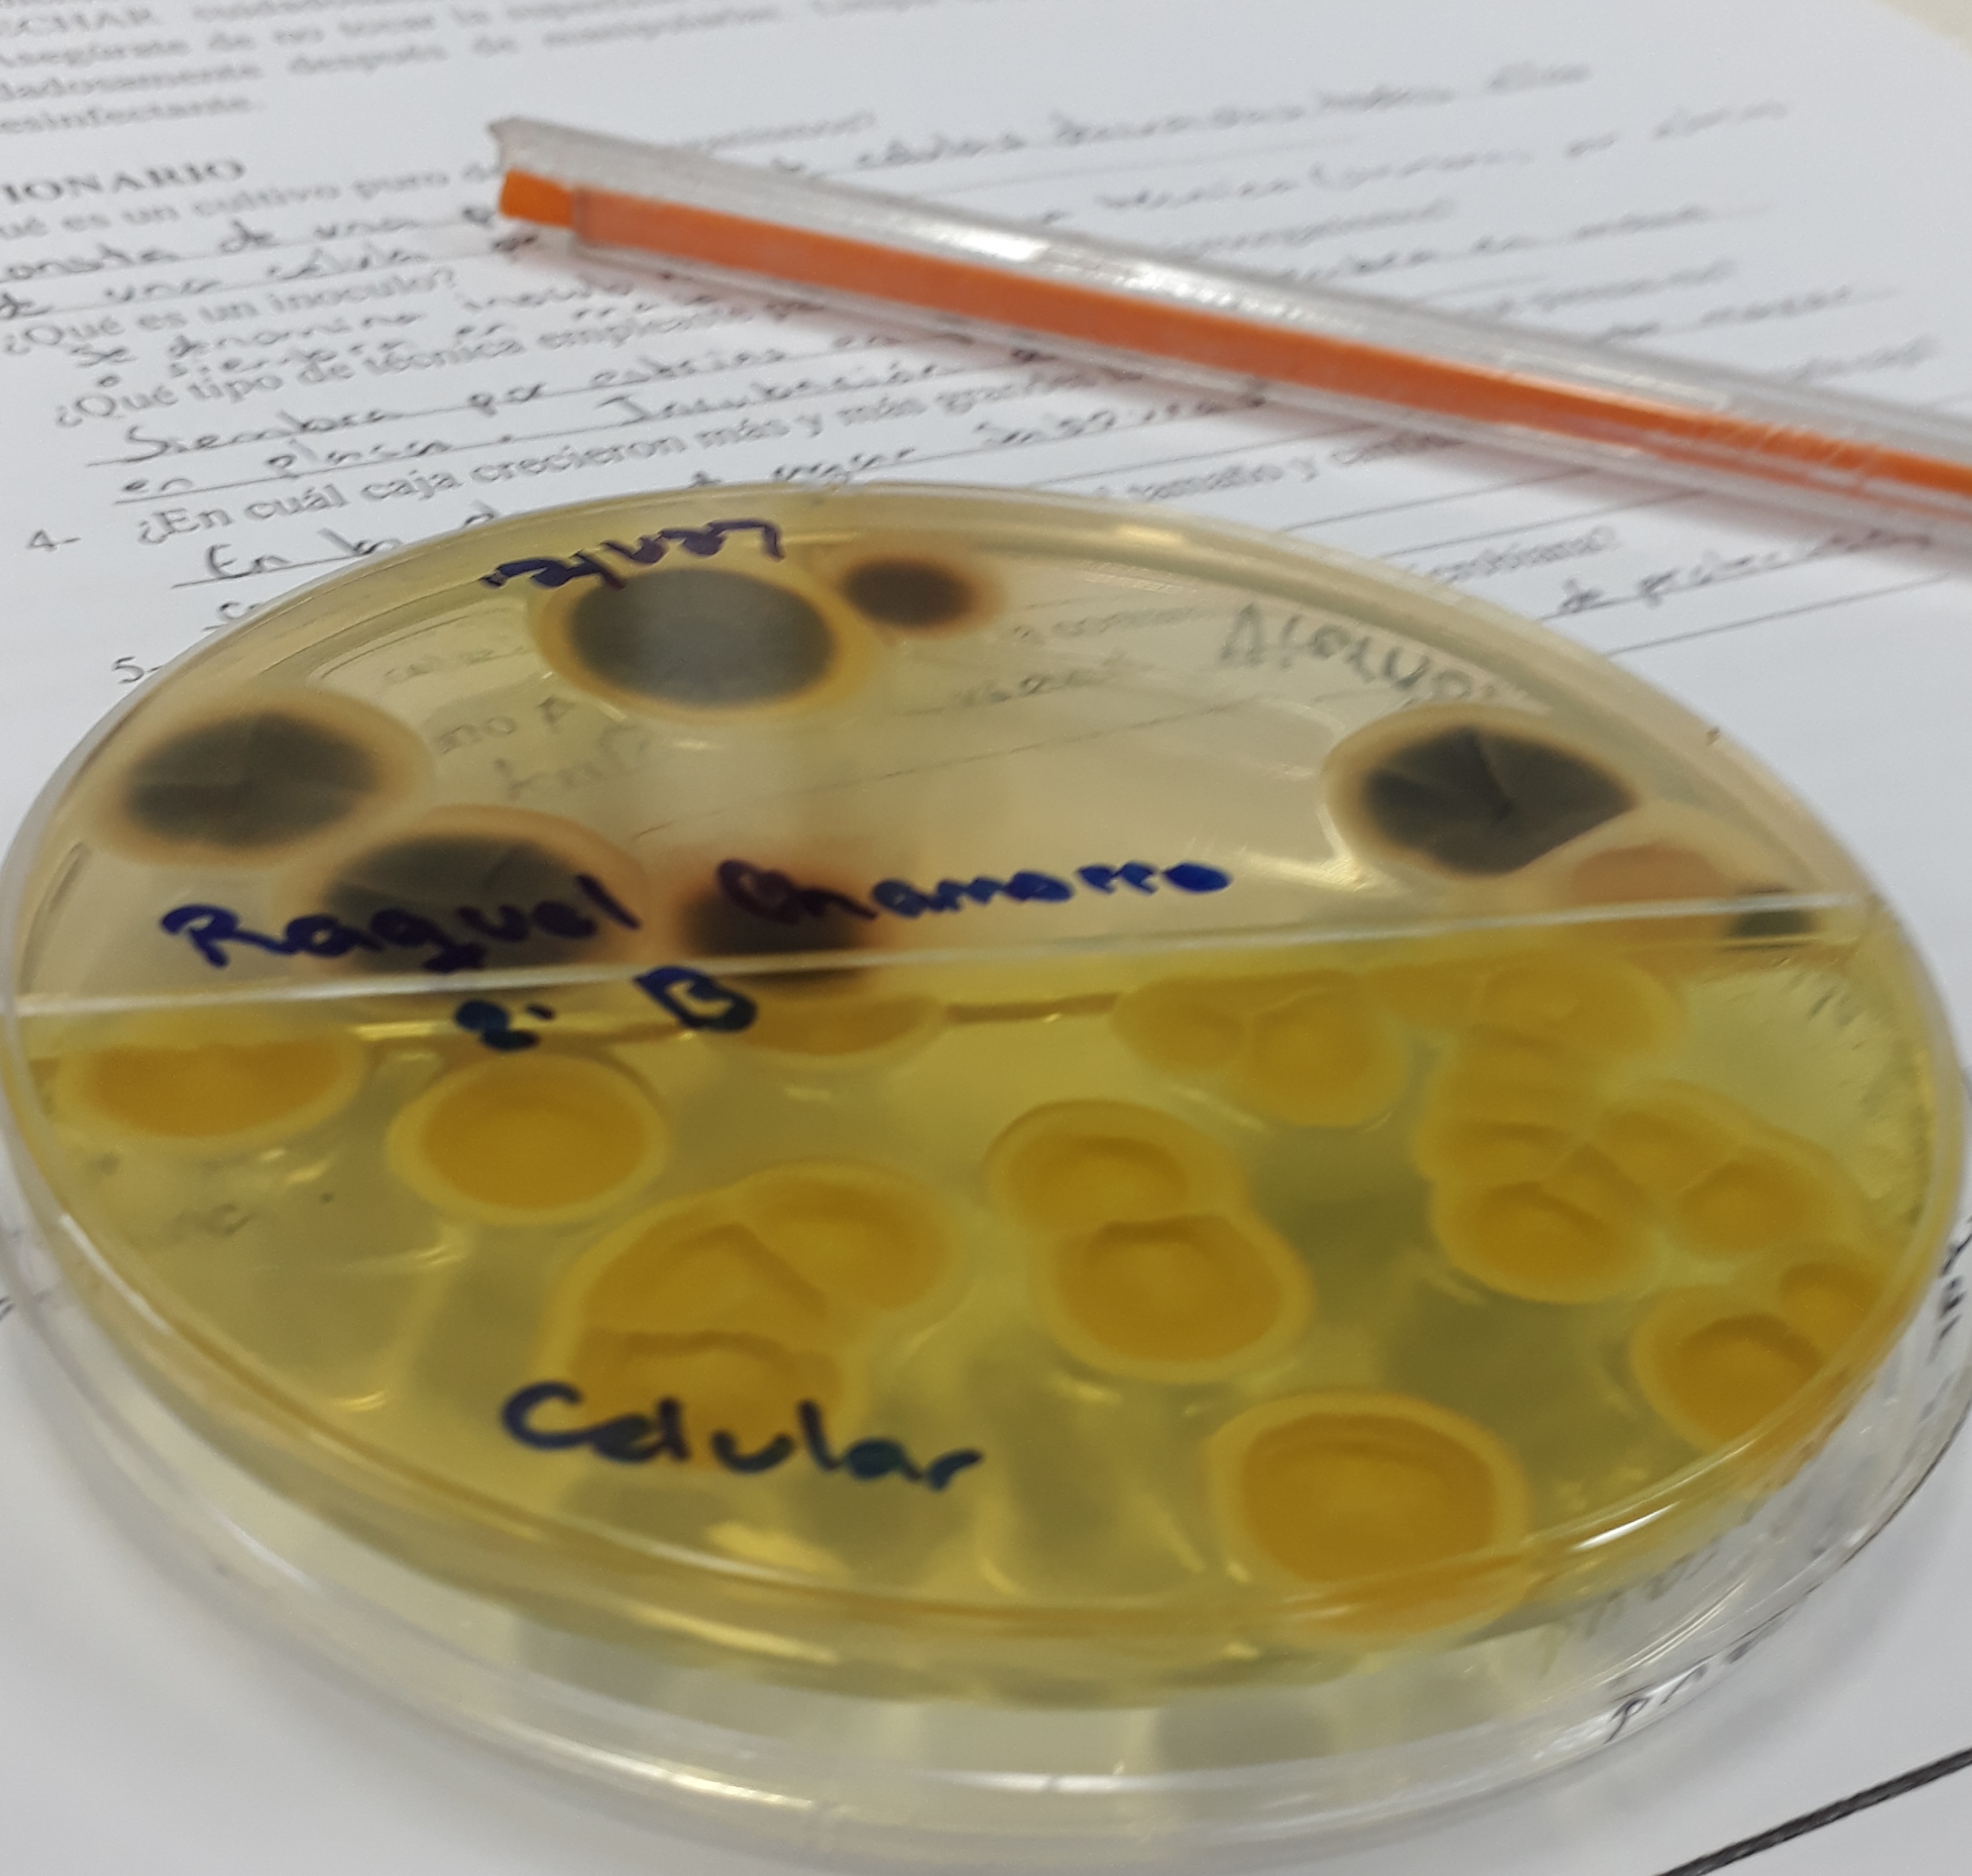
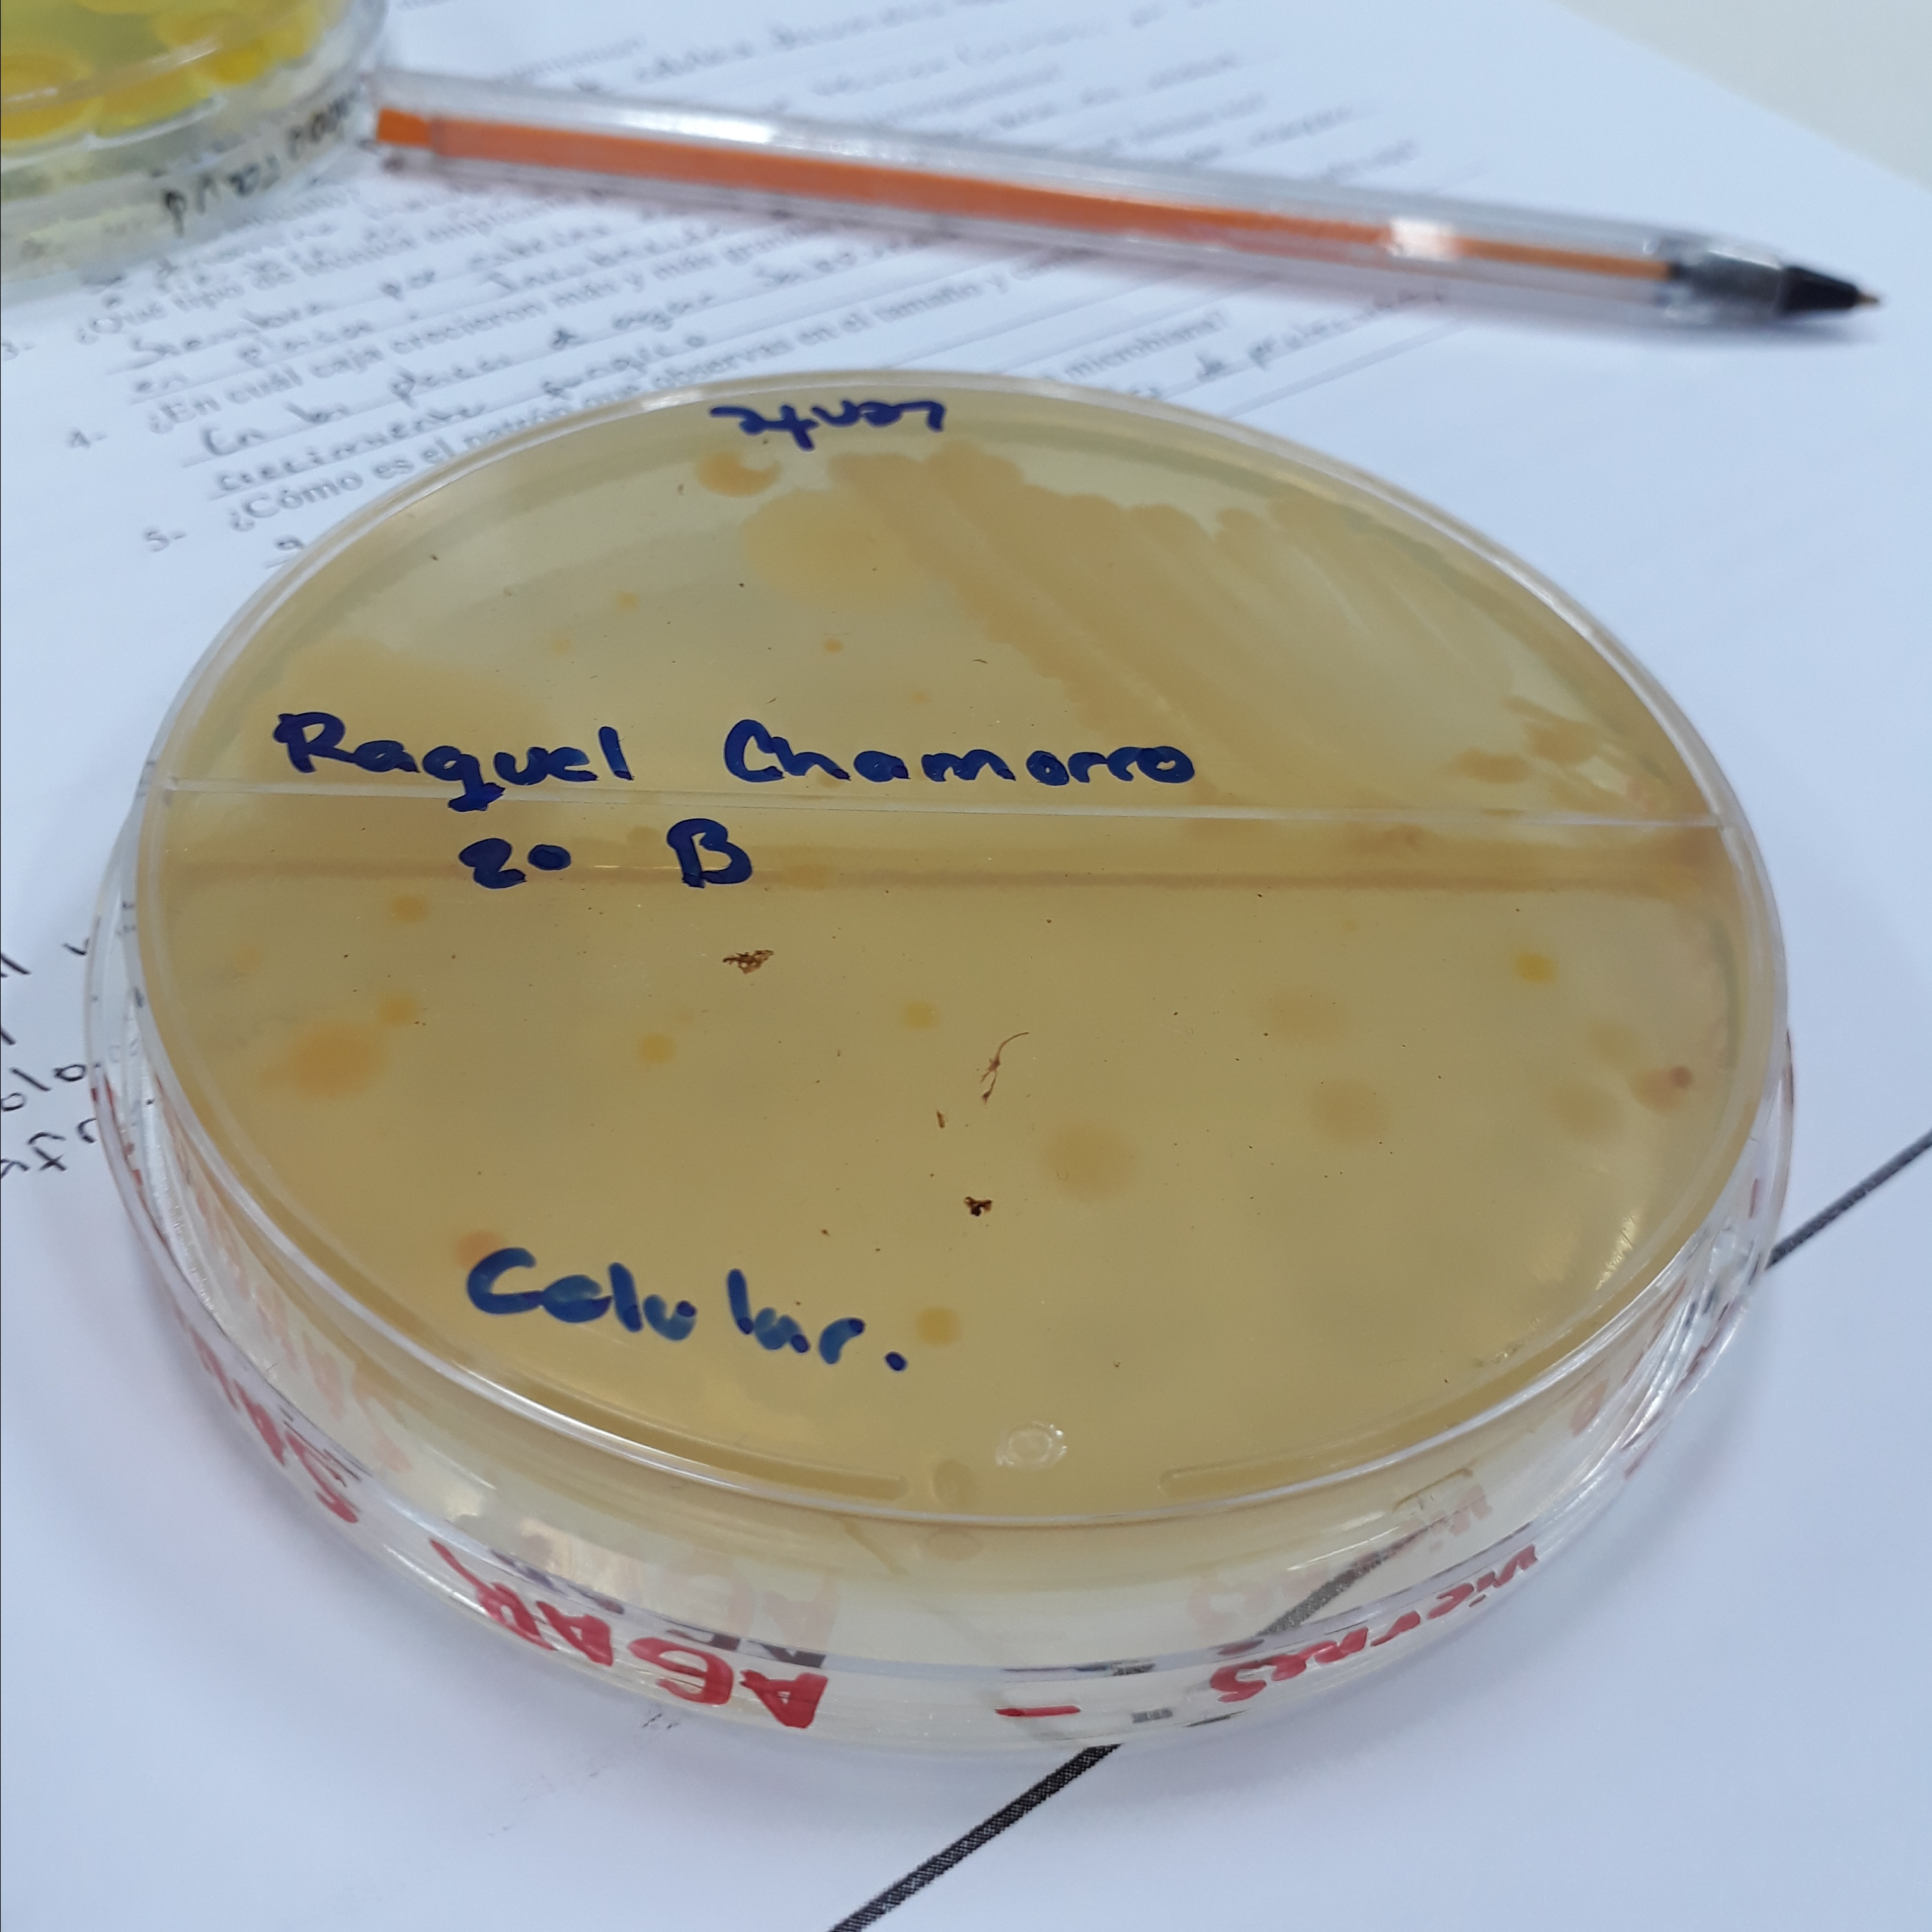

Bacterias Y Hongos. 🔬🔍
Buenas noches amigos!!
Hoy quiero compartir con ustedes algo sorprendente que me toco aprender en la universidad.
Se trata de las Bacterias y hongos que están constantemente a nuestro alrededor.
Con ayuda de las Dras Bioquimicas preparamos algunos alimentos artificiales para que ellos crezcan y se reproduzcan y asi poder observarlas.
Estas sustancias son preparadas unicamente en el laboratorio de Microbiología.
El alimento artificial utilizado para que ellos crezcan se conoce como Medio de cultivo, y el crecimiento de esos microorganismos se conoce como Cultivo.
- Temperatura.
- Grado de Humedad.
- Presión de oxígeno adecuado.
- Grado correcto de Acidez y Alcalinidad.
- Liquido.
- Semisolido.
- Sólido.
Las muestras las tomé de mi celular y mis gafas (lentes)
El resultado fue éste
Medio de Cultivo - Agar Sabouraud - Para crecimiento de Hongos.
Medio de cultivo - Agar Sangre - Para crecimiento de Bacterias.
Sinceramente me sorprendí con el crecimiento de los hongos, pero es normal porque lo que hicimos es alimentar a estos microorganismos para poder observarlos.
Nuestro alrededor constantemente está contaminado.
Lo que podemos hacer para evitar o disminuir la contaminacion de nuestro ambiente es desinfectar constantemente, esterilizando y usando materiales de proteccion.
Y
HASTA LA PRÓXIMA

Woow...ni idea tenia de estas cosas raras jaja gra ias por enseñarnos. Exitos en tu carrera.
Sii! Vivimos con ellos, son nuestros compañeros de vida silenciosamente jajaja. Muchisimas gracias!!
Miedo jajaja!!!tanto asi son visibles estas bacterias o solo porque alimentaron es que ceecen asi?
Gracias por compartir
Jajaja es visible solo porque las alimentamos, éstas son las bacterias que constantemente están a nuestro alrededor y no nos damos cuenta, convivimos con ellas.
Interesante post, como sabemos la limpieza es primordial!!
Asi es! La limpieza habla mucho de nosotros!
Muy interesante, nos da la pauta que nuestro cuerpo es un héroe. He viajado toda mi vida, y as impresionante pienso quien se habrá sentado aquí, o quien lo habrá tocado. Especialmente en los subterráneos de Bs As., Bueno tomaré esterilizante je je y que Dios nos guarde. Gracias por esta información
Jajaja sii! Asi mismo es, Dios nos guarda dia a dia y cosas que ya no estan a nuestras posibilidades de cuidar sabemos que él hara.
En nuestro cuerpo viven millones de bacterias, ellas anticipan cambios en su entorno. Se depositan sobre la materia orgánica muerta para alimentarse. Interesante Post.
Sii! Muchos microorganismos inofensivos tambien. Gracias por el apoyo!!
Es asommbroso como convivimos con hongos y bacterias. Y muchas de las especies son necesarias pera un equilibrio biológico. Lindo post.
excelente informacion no estaba al tanto de esta informacion que deberíamos saber estaos rodeados de bacterias jajaja, gracias por compartir.
Jaja sii!! Debemos tener cuidado con ellos pero en especial tener cuidado con nuestro aseo y la limpieza del ambiente en el que vivimos
Bueno si tenemos conducta en la limpieza, la cual es primordial en todo orden, gracias por compartir.
Asi es!! Lo mejor es la limpieza, evitamos el crecimiento de muchisimas especies de microorganismos.
thank you
Gracias a ti por traernos este tipo de información, la limpieza es muy importante
Sii! La limpieza siempre debemos cuidar ya que estás bacterias son invisibles a simple vista.